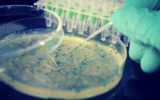

10 августа
-
15:35
У переболевших COVID-19 нашли иммунные нарушения, которые сохраняются полгода
 COVID-19
COVID-19
-
14:48
Биоклей на основе ракушек останавливает кровотечение за 15 секунд
 Наука
Наука
-
14:22
В ближайшие годы вымрут такие виды рыб, как сельдь и сардина
 Наука
Наука
-
14:07
Samsung представила 5-нм двухядерный чипсет Exynos W920
 Новости
Новости
-
13:47
«Холодные» звезды теплее и менее уникальные, чем считалось
 Наука
Наука
9 августа
-
16:39
Apple будет искать запрещенный контент в фотографиях пользователей: как это будет работать
 Кейсы
Кейсы
-
12:31
Создан новый способ обнаружения альфа-варианта SARS-CoV-2 в сточных водах
 COVID-19
COVID-19
-
12:07
Посмотрите на тройной ударный кратер на Марсе
 Наука
Наука
-
11:46
В МIT запрограммировали воспоминания в бактериальные клетки, переписав их ДНК
Наука
Наука
-
10:28
Ученые разработали тепловизор, встраиваемый в смартфон
 Новости
Новости
6 августа
-
21:44
Миссию по «перехвату комет» запустят уже в концу десятилетия: зачем она нужна
 Кейсы
Кейсы
-
16:45
Ученые придумали, как преобразовывать отработанное тепло в электричество
 Наука
Наука
-
15:55
Huawei запатентовала смартфон с растягивающимся дисплеем
 Новости
Новости
-
15:15
Новые умные часы растворяются в воде за полтора дня
 Новости
Новости
-
14:47
В Windows 11 появилась функция, которая помогает сосредоточиться на работе
 Новости
Новости
-
14:27
Астрономы заметили в далеком космосе необычные структуры
 Наука
Наука
-
11:41
Химики создали светящийся аэрогель
 Наука
Наука


